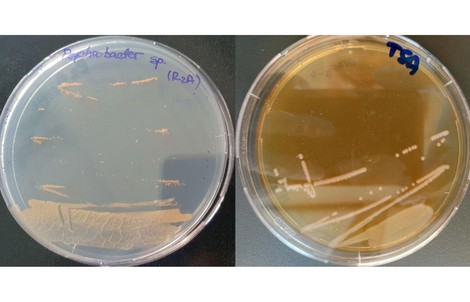
Sinh vật cực nguy hiểm ra từ băng hang động 5.000 năm

Nhưng thời điểm này khi dịch bệnh đã lùi dần, nhiều ý kiến cho rằng, rất cần tăng lương để thúc đẩy tăng tổng cầu, thúc đẩy nền kinh tế. Chưa kể vừa qua, lạm phát tăng cao, nhiều nhân lực nhất là ngành giáo dục, y tế nghỉ việc do thu nhập không đủ sống.
Không thể nợ mãi
Tại Diễn đàn Kinh tế - Xã hội Việt Nam 2022 vừa qua, PGS.TS Vũ Sỹ Cường (Học viện Tài chính) đề nghị, năm 2023 - 2024 xem xét ngay việc tăng lương cho cán bộ, công chức, viên chức (CBCCVC) để tạo ra sự kích thích mới, bởi hiệu quả cao sẽ được tạo ra ngay từ việc tăng lương - chính sách được cho là đơn giản, dễ thực hiện và trực tiếp.
Ước tính tổng thu ngân sách nhà nước 8 tháng năm nay đạt tới 1,2 triệu tỉ đồng, bằng 85,6% dự toán năm và tăng 19,4% so cùng kỳ năm trước. Như vậy, dù còn 4 tháng nữa mới hết năm nhưng số thu ngân sách đã đạt khả quan so với kế hoạch cả năm, có nghĩa không phải chúng ta không có khả năng trả món nợ tiền lương đã nợ suốt 3 năm qua.
Đề xuất này nhận được đồng tình của đông đảo chuyên gia, nhà quản lý và nhất là cán bộ cơ sở. Khi mặt bằng giá mới đã được hình thành sau các biến động liên tục của giá xăng, dầu, lạm phát cộng dồn 3 năm qua đã khiến giá trị đồng tiền hao hụt lớn, trong khi lương CBCCVC đáng lẽ được tăng từ tháng 7/2020 theo lộ trình, nhưng vì những khó khăn do đại dịch nên phải "tạm dừng", dừng qua năm 2021 và sang cả năm nay. Các ý kiến đều nhận định, đó là sự hy sinh của những người hưởng lương và cũng là "món nợ" và không có lý do gì để kéo dài thêm nữa.

Trưởng Phòng Nội vụ UBND quận Long Biên Nguyễn Thị Thu Hằng cho rằng, tăng lương ngay trong năm tới sẽ là một động lực giúp duy trì, thu hút lực lượng lao động khối cơ quan Nhà nước và đơn vị sự nghiệp công lập (SNCL), vì đang có tình trạng nhiều CBCCVC xin thôi việc, ra ngoài làm.
Với mặt bằng chung ở các đô thị lớn như Hà Nội, nhiều CCVC hiện có thu nhập đúng là thấp; nếu vẫn trì hoãn tăng lương sẽ ảnh hưởng không nhỏ tới tâm lý chung của đội ngũ này. Thực tế làm việc trong hệ thống cơ quan Nhà nước và đơn vị SNCL chịu rất nhiều áp lực về khối lượng công việc và cả chế độ đãi ngộ…
Ngay tại Phòng Nội vụ quận Long Biên, CBCC hằng ngày làm việc không bao giờ chỉ trong 8 tiếng mà thường xuyên phải làm thêm giờ… có ít thời gian nghỉ ngơi để tái tạo sức lao động chứ chưa nói đến đãi ngộ bằng tăng thu nhập. Dù ở quận, phúc lợi xã hội từ tiết kiệm chi được thực hiện rất tốt, nhưng vẫn không ít CBCC không còn thấy gắn bó hay có sức hút từ công việc, nhiều phòng ban chuyên môn vẫn thiếu CBCC nhưng rất khó tìm được người làm việc.
"Dù trước mắt tăng lương chỉ chút ít, chưa tương xứng với tốc độ trượt giá, nhưng sẽ là động viên rất kịp thời, giải pháp thúc đẩy rất lớn để tạo yên tâm, cống hiến của đội ngũ CBCCVC. Sau đó, cần có lộ trình tăng lương tiếp theo mới tạo được niềm tin của người lao động" - bà Nguyễn Thị Thu Hằng thẳng thắn bày tỏ.
Từ thực tế địa phương, Chủ tịch UBND phường Phố Huế (quận Hai Bà Trưng) Phan Bá Tường cũng chia sẻ, hiện khối lượng công việc ngày càng lớn từ khi phường chuyển mô hình quản lý sang chính quyền đô thị, trong khi thu nhập thấp không đủ trang trải cuộc sống khiến khối hành chính sự nghiệp có nhiều CBCCVC xin thôi việc để ra ngoài làm.
Đã có trường hợp CBCC phường xin chuyển công tác để có mức thu nhập khá hơn, đảm bảo chi tiêu. Tại phường, áp lực công việc rất lớn ở tất cả các mảng, nhưng số CBCC giảm đi, mà không có thu nhập tăng thêm.
"Nguyện vọng của CBCC cơ sở là bên cạnh cấp bách tăng lương theo lộ trình sau mấy năm bị trì hoãn, rất cần có thu nhập tăng thêm, tăng phụ cấp so với trước, nhất là cho lãnh đạo UBND phường là người đứng đầu thực hiện chính quyền đô thị phải chịu trách nhiệm ngày càng cao (hệ số phụ cấp cho Chủ tịch UBND phường hiện chỉ được 0,25 không phù hợp).
Cần quan tâm lực lượng lao động làm việc trực tiếp, đặc biệt từ khi thực hiện chính quyền đô thị, công chức phường đã trực thuộc quận rồi, nên được hưởng cơ chế chính sách giống như công chức cấp quận, mới cải thiện đời sống" - ông Phan Bá Tường cho hay.
Kích thích chất lượng nguồn lực
Nguyên ĐB Quốc hội Bùi Thị An cho rằng, hơn 2 năm qua phải gồng mình chống dịch Covid-19, từ CBCC tới mọi người dân đã chia sẻ khó khăn với Nhà nước, nên việc trì hoãn tăng lương là hợp lý, nhưng hiện đã trở lại trạng thái bình thường mới, dù lạm phát được kiềm chế nhưng giá cả vẫn leo thang, đời sống CBCCVC rất khó khăn.
Nếu thu nhập không đủ đảm bảo đời sống ở mức tối thiểu, sẽ khiến họ phân tâm, không tập trung được vào công việc. Do đó, việc nghiên cứu tăng lương cho CBCCVC ngay từ đầu năm sau là đòi hỏi rất gấp rút, nhằm nâng cao điều kiện làm việc, kích thích chất lượng nguồn lực, giúp CBCCVC yên tâm làm việc với năng suất cao hơn.
Cũng theo bà Bùi Thị An, việc tăng lương cần có lộ trình, cam kết rõ ràng, vì là nhân tố vô cùng quan trọng để tái sản xuất sức lao động, tăng năng suất. Nếu Nhà nước chưa có điều kiện thì dù trước mắt tăng lương ít nhưng sẽ là nguồn động viên vô cùng lớn để người lao động thấy công sức mình bỏ ra được ghi nhận.
Phó Chủ tịch Tổng LĐLĐ Việt Nam Ngọ Duy Hiểu cũng xác nhận thực tế là thu nhập của CCVC khu vực công còn thấp, cộng thêm việc phân phối cứng nhắc, cào bằng chính là 1 trong 5 nguyên nhân dẫn đến chuyển dịch nhân lực từ khu vực công sang khu vực tư. Là thành viên Ban Chỉ đạo T.Ư cải cách tiền lương, BHXH và ưu đãi người có công, ông bày tỏ mong muốn lương CCVC, LLVT sẽ được tăng ngay vào đầu hoặc cùng lắm là giữa năm 2023. "Trong nền kinh tế thị trường nhiều thành phần, việc chuyển dịch lao động từ khu vực công sang tư hoặc ngược lại là việc bình thường, nhưng chuyển dịch nhiều với tỷ lệ đáng kể sẽ dẫn đến thiếu hụt nguồn nhân lực ở một số ngành, lĩnh vực khu vực công như thời gian qua. Do đó, cần đánh giá kỹ để sớm có giải pháp khắc phục. Mỗi CC, VC chuyển từ khu vực công sang khu vực tư đều có lý do riêng, trong đó có vấn đề thu nhập" - ông Ngọ Duy Hiểu nêu ý kiến.
TS Nguyễn Hữu Dũng – nguyên Viện trưởng Viện Khoa học Lao động và Xã hội, Bộ LĐ- TB-XH:
Tiền lương thấp nhất của cán bộ, công chức không thấp hơn lương tối thiểu vùng
Hiện nay, phân hóa tiền lương và mức sống của người hưởng lương giữa khu vực công và khu vực thị trường rất lớn nên dẫn đến hậu quả rất nguy hại là: Để bù đắp tiền lương, người hưởng lương khu vực công sẽ không chuyên tâm trong công việc, nảy sinh tiêu cực, bỏ bê công việc, thậm chí tham nhũng quyền lực rất lớn. Hoặc một bộ phận không nhỏ có xu hướng bỏ khu vực công sang khu vực thị trường, nhất là người có trình độ cao, người tài; đồng thời không thu hút được đối tượng này vào khu vực công.
Năm 2023, dịch bệnh Covid-19 chưa thể chấm dứt, nền kinh tế phục hồi nhưng còn rất khó khăn. Bởi vậy, việc cải cách tiền lương theo lộ trình mà Nghị quyết số 27-NQ/TW xác định cũng không dễ dàng; do đó điều chỉnh bước đi để bảo đảm tính khả thi. Trước mắt cần thực hiện ngay việc bảo đảm tiền lương thấp nhất của cán bộ, công chức, viên chức không thấp hơn mức lương bình quân thấp nhất (tối thiểu) của 4 vùng khu vực DN. Đồng thời, thực hiện giảm biên chế khu vực công theo quy định và chuyển mạnh những đơn vi sự nghiêp cung cấp dịch vụ công sang thực hiện tự chủ về tiền lương…